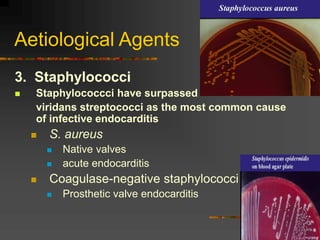
Aetiological Agents
3. Staphylococci
 Staphylococcci have surpassed
viridans streptococci as the most common cause
of infective endocarditis
 S. aureus
 Native valves
 acute endocarditis
 Coagulase-negative staphylococci
 Prosthetic valve endocarditis

Endocarditis is an infection of the inner lining of the heart. It commonly affects the heart valves, forming vegetations. It is classified as acute/subacute or chronic based on presentation and progression. The pathology is vegetations composed of platelets, fibrin, microorganisms and inflammatory cells. It is diagnosed using Duke criteria including blood cultures, echocardiogram findings and clinical features. Complications include heart failure, emboli and death. Treatment involves long-term antibiotics targeting the causative organism along with possible surgery. Prevention includes antibiotic prophylaxis for at-risk patients during invasive procedures.